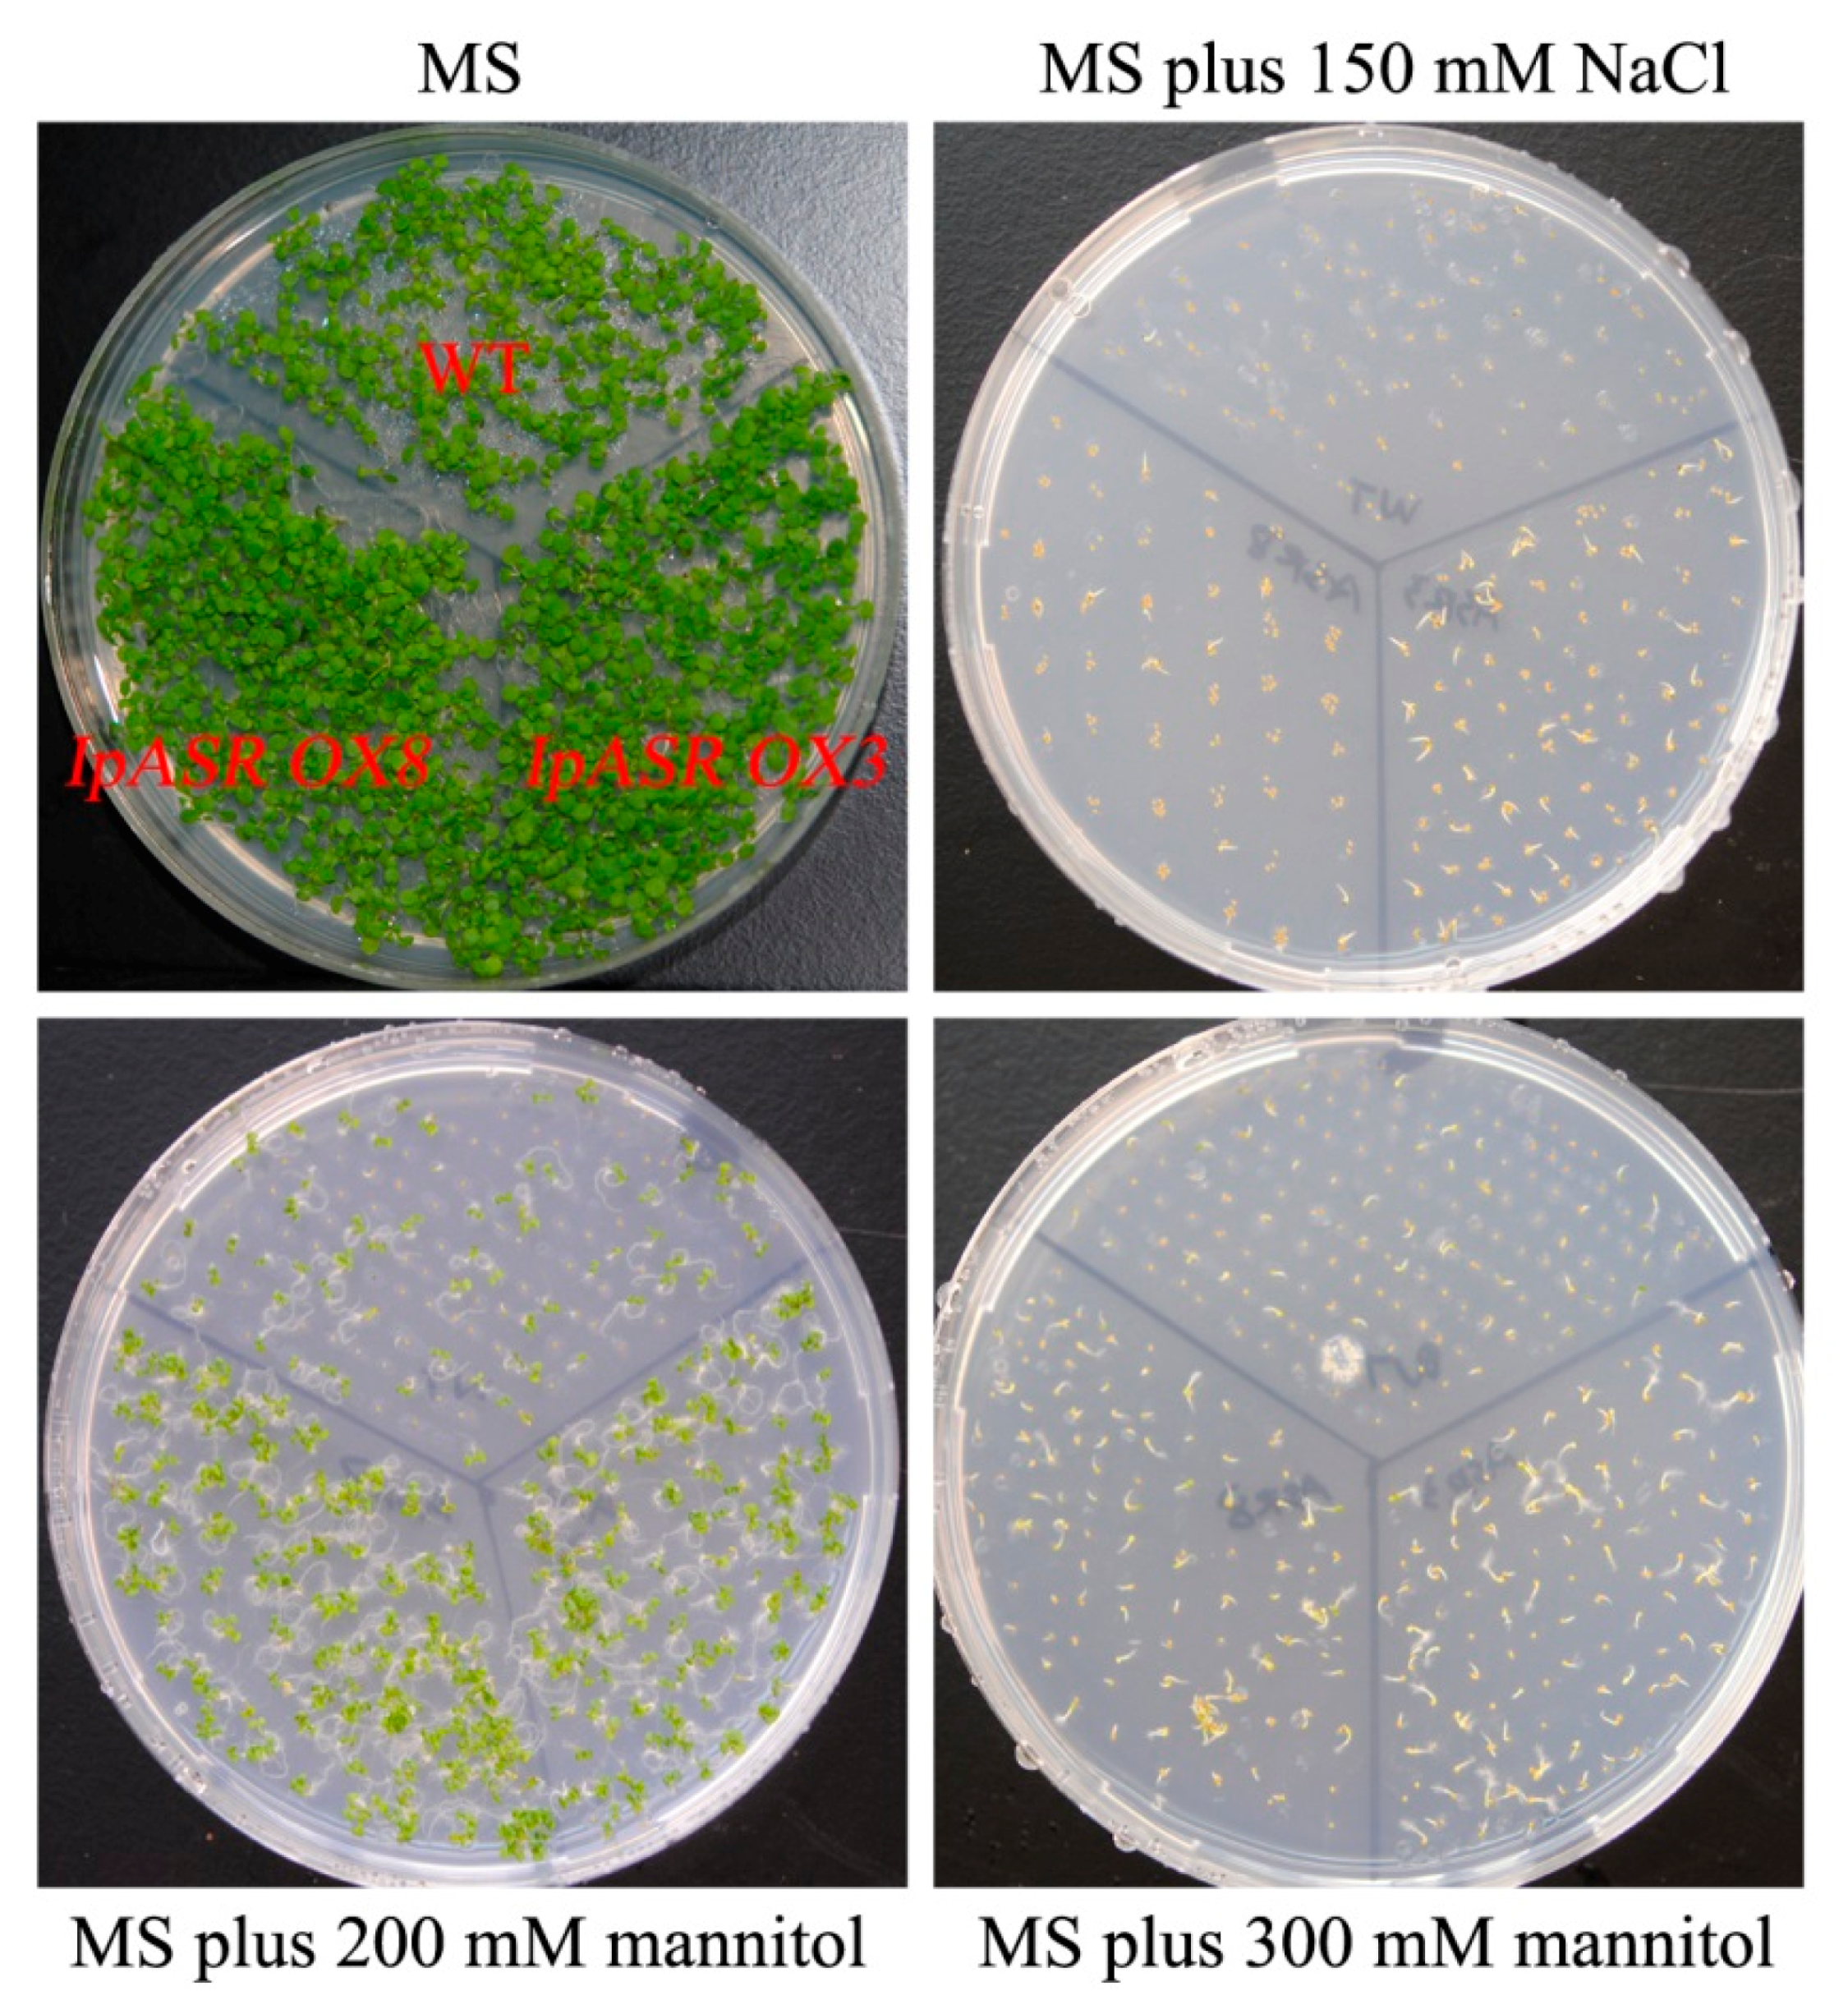
Ijms 19 02252 g009

1. Introduction
Due to the immobility of plants, their growth and development is frequently influenced by external environmental signals, particularly by certain biotic or abiotic stresses. The response of plants to stress mainly involves the following steps: The perception and transduction of stress signals and the induction of the expression or synthesis of the response gene or protein, resulting in cellular changes in physiological and biological characteristics, eventually decreasing the damage caused by stress [
1]. Among these responses, the regulation of the expression of stress-related genes is a vital step for the survival or tolerance of plants in adverse conditions. The isolation and characterization of stress-tolerance genes provides a foundation for the genetic improvement of plants and crops [
2].
ASR (
abscisic acid,
stress,
ripening-induced) genes are plant-specific small gene families that are mostly involved in the response to abiotic (mainly drought and salinity) stresses and fruit ripening [
3]. The adaptation of many plants and crops to stressful environments in the context of environmental degradation and climate change is being increasingly studied in an attempt to improve stress tolerance and isolate candidate stress-related genes for plant genetic engineering.
ASR proteins occur in many plant species and belong to a family of hydrophilic proteins that have important roles in the response to abiotic stresses. All ASRs harbor the ABA/WDS (abscisic acid/water deficit stress) domain (Pfam entry PF02496) as a common denominator, indicating that they might have similar biological functions in the response of plants to dehydration or the abscisic acid (ABA) signaling pathway [
4]. Since ASRs may not only function as transcription factors, but also as intrinsically unstructured chaperones possessing similar plant LEA (late embryogenesis abundant) protein characteristics, some reporters classified as ASR proteins have been placed into the LEA protein group because of their small size, physicochemical properties, and participation in stress pathways [
5]. While with a distinguished feature from LEA family, a large multigene family, the ASR family is obviously absent from Brassicaceae plants (including
Arabidopsis), and usually comprise few members in other plants. The first member of
ASR, tomato
Asr1, was identified by screening a tomato fruit cDNA library using a cDNA differential hybridization approach, with accumulated transcripts observed in the ripening fruit, water-stressed leaves, or under ABA treatment, hence its name [
6]. Following this, a fairly large number of
ASR orthologs were characterized from many plant species along with the advance of the Plant Genome Project [
7,
8,
9,
10].
Plant-specific
ASR genes are typically upregulated by a wide range of factors, including drought, cold, salt, ABA, and injury, in addition to the plant response to developmental and environmental signals. Drought and salinity are two common abiotic stressors that often challenge plant growth and development, thereafter triggering complex multicomponent signaling pathways to restore cellular homeostasis and promote plant survival [
11]. Recent studies in many plants suggest that different
ASRs could elevate the tolerance of transgenic plants to high salinity and dehydration. For instance, the
MpAsr from
Musa paradisiaca (banana) conferred improved osmotic tolerance to transgenic
Arabidopsis [
12].
Salicornia brachiata is an extreme halophyte that can survive in salty marshes in coastal areas.
SbASR-1 from
S. brachiata conferred enhanced salinity and drought endurance in transgenic tobacco and groundnut [
13,
14].
Suaeda liaotungensis is also an extreme halophyte that is mainly distributed on saline and alkaline lands in Heilongjiang province and the Inner Mongolia province in China. The
SlASR from
S. liaotungensis also elevates salinity and drought tolerance in transgenic plants when overexpressed in
Arabidopsis [
15]. The gramineous plants
Setaria italica and
Brachypodium distachyon are both drought resistant plants.
SiASR4 [
16] from
S. italica and
BdASR1 [
9] from
B. distachyon both enhanced salt and drought tolerance when they were separately overexpressed in
Arabidopsis or tobacco.
Ipomoea pes-caprae L. (Convolvulaceae) is a wild perennial lianaceous herb that naturally occurs in seashore areas of tropical or subtropical regions worldwide. It exhibits high nutrition uptake and utilization efficiency and strong resistance to salt and drought, and hence has been used as the first “green barrier” for sand fixation, island-greening, and the ecological restoration of coastal regions and islands and reef construction [
17]. As evidenced by its habitat,
I. pes-caprae is also an extreme halophyte, which is considered to be the best resource for characterizing stress-tolerance genes and promoters [
18]. These are then ultimately introduced into non-halophytic crop species to improve their performance under saline conditions [
19]. In this study, we mainly focused on the characterization of
IpASR from
I. pes-capraei, and performed transgenic assays in
Escherichia coli and
Arabidopsis thaliana to functionally validate this gene under salt/drought and other abiotic stress conditions.
3. Discussion
Till now, only a few plant
ASRs have nevertheless been characterized in terms of biological function, with most of them being involved in water deficit stress [
4]. When plants suffer from water deficit (such as drought, freezing, high salinity, or ABA signaling caused by other stresses),
ASR transcripts are induced, and a large amount of ASR proteins accumulate to reduce the cellular damage caused by the stresses, or to trigger the expression of some other stress response genes and the associated signaling pathways. The exact functions of ASR proteins remain unknown, but have been found to play an important role in improving the adaptability of plants to different abiotic stresses, including water deficit stress [
3,
24], as well as in regulating plant development and metabolism [
4,
25].
In the present work, a novel
ASR gene,
IpASR, was isolated and characterized from the extreme halophyte
I. pes-caprae for the first time. Bioinformatics analyses indicated that IpASR is a highly hydrophilic, intrinsically disordered, and highly stable protein, possessing similar characteristics to LEA proteins. The ABA/WDS motif (PF02496) and other characteristics (
Table 1) are regarded as key factors in reducing water loss in plants under stress conditions, which is equivalent to the role of hydration buffers in maintaining water balance [
26,
27,
28]. Combining with the sequence alignment of different ASR members (
Figure 1), we can infer that the ABA/WDS motif is highly conserved not only in sequence and secondary structure, but also in biochemical and biological functions, even till now there is no relevant reports about its specific functional mechanisms in plants.
Sequence phylogenetic analysis of IpASR and other plant proteins (
Figure 2) showed that IpASR is highly homologous to InASR from morning glory (
Ipomoea nil) [
29], another Convolvulaceous plant. The expression of
InASR in the corolla was upregulated along with flower senescence, while the transcription of
IpASR also showed a high level of accumulation in the blooming flower of
I. pes-caprae, indicating that it might be involved in the regulation of flower development and senescence as well as dehydration processes. Furthermore, IpASR also showed high homology with another two halophyte members, namely SbASR-1 (ACI15208.1) from
S. brachiate [
13,
14] and SlASR (AGZ20206.1) from
S. liaotungensis [
15], both of which exhibited a strong positive correlation between transcript accumulation (overexpression assay in tobacco, groundnut, and
Arabidopsis) and elevated resistance for salt and drought tolerance. The phylogenetic tree did reveal the close evolutionary relationship between three Convolvulaceous plant ASRs, including IpASR (
I. pes-caprae), InASR (
I. nil), and CsoASR (
C. soldanella). However, due to the phylogenetic tree of ASR proteins was constructed based a few members, the evolutionary relationships of ASRs between glycophyte and halophyte, or monocot and dicot, could not be reflected in this tree. In addition, according to reports by Philippe et al. [
30] and Cortés et al. [
31], the diversity of the
ASR genes was globally low in the context of drought tolerance, and different
ASR members undertook different degrees of evolutionary and natural-selection pressure, subsequently presented different haplotype diversity or gene diversity. In summary, the above-mentioned plant ASRs are all involved in water deficit stress. Since the sequence homology usually reflects the functional similarities of different proteins, our bioinformatics analysis revealed that IpASR could be involved in the adaptation of
I. pes-caprae to extreme saline and arid environments in tropical and subtropical coastal regions.
Salt, drought, and other abiotic stress factors ultimately result in the significant accumulation of ROS, thereby evoking the antioxidant system of plants [
22]. Although there is a lot of evidence regarding the participation of plant ASRs in the response to abiotic stress, there is some direct evidence suggesting that plant ASRs have roles in the antioxidant activity of plants [
4]. For instance, the overexpression of wheat
TaASR1 in tobacco enhances the expression of ROS-related and stress-responsive genes under osmotic stress, thereby improving the drought tolerance and MV resistance of tobacco [
28]. The rice ASR1 can both scavenge ROS [
32] and act as a transcription factor regulating aluminum responsive genes in rice [
33]. A soybean ASR protein can bind metal ions and provide cellular antioxidant protection [
34]. In our previous research, IpASR could elevate H
2O
2 tolerance when expressed in yeast (data not published), whereas in this report the induction of IpASR in
E. coli resulted in the transgenic
E. coli exhibiting higher tolerance than the control not only to NaCl and sorbitol, but also to H
2O
2. This further implies that the IpASR protein not only improves the resistance of
E. coli to osmotic stresses via its highly hydrophilic ability, but at the same time also alleviates the toxicity of ROS to
E. coli cells in an unknown manner, thus improving the antioxidant ability of
E. coli.
Based on its physical and chemical properties, IpASR exhibits a heightened level of hydrophily, mainly mediated by high contents of hydrophilic amino acids, such as glutamic acid (17.67%), lysine (11.63%), and glycine (11.16%). Combined with the ABA/WDS domain, this feature ensures the functionality of IpASR in water deficit. Beside that there is still an important motif, designated as a histidine-rich motif (also named zinc-binding domain) at the N-terminal, which probably mediated the metal-binding (including Zn
2+, Fe
3+, Ni
2+ and Cu
2+) and in turn underwent conformational transition from unfolded to folded, then prevented the formation of ROS, or changed the protein’s solubility [
7,
34]. By analyzing the ASR sequences, we discovered that most ASRs at the N-terminal possess the His-rich motif, as does IpASR. Here we can speculate that this conserved His-rich motif might play some roles in cellular antioxidant responses when challenged by environmental stresses. However, there are still some other ASR members, such as two halophyte ASRs, namely SlASR from
S. liaotungensis and
SbASR-1 from
S. brachiate [
13,
14,
15], which lack this typical motif. This further illustrates that there might be other mechanisms mediating the response of ASRs to ROS scavenging and abiotic stresses.
The transcription patterns of genes closely reflect the biological function of the genes. Our research indicated that the expression of
IpASR was induced by high-salt (300 mM NaCl), osmotic (300 mM mannitol), oxidative stress (MV), low temperature (0 °C), and ABA treatment, which further indicated that
IpASR is an important stress response gene in
I. pes-caprae. Additionally, the IpASR protein is located in the nucleus, suggesting that this protein might be a chaperone or transcription factor in the cell nucleus that alleviates the harm of environmental stress to plant cells. We performed a transcriptional activity assay in yeast, which allowed us to speculate whether IpASR exhibits transcription factor activity and if the action domain is located at the N-terminal (
Figure 6).
Over the past few decades, several model plants, such as tobacco and
Arabidopsis as well as microorganisms, have been used to carry out the functional validation and characterization of genes from plants [
13,
15,
16,
35,
36]. Here, we expressed IpASR in
E. coli for the primary functional validation of IpASR in water deficit and anti-oxidation (
Figure 4). To further clarify the function of
IpASR under abiotic stress conditions,
IpASR was overexpressed in
Arabidopsis plants (
Figure 7). Phenotypic analyses indicated that
IpASR in
Arabidopsis considerably enhances salt and osmotic resistance (
Figure 8,
Figure 9,
Figure 10 and
Figure 11) and also alleviates ROS toxicity (Figures 13 and
Supplementary Materials Figure S1). ASR proteins play important roles in abiotic stress tolerance in most plants, as observed for SiASR4, TaASR1, OsASR1/5, and ZmASR1 [
16,
28,
32,
33,
37]. Our research indicated that the overexpression of
IpASR in
Arabidopsis resulted in stronger tolerance to salt/drought in combination with reduced ROS accumulation and the elevation of the cellular antioxidative enzyme system. Here, we presumed that IpASR could act as a protective protein to maintain enzyme activities or to obstruct ROS production by binding to metals. Furthermore, IpASR exhibits transcription activity (
Figure 6), which implies that the accumulation of IpASR affects the expression of some genes. We also assessed the transcripts of some antioxidative genes, and their expression patterns all changed both under control and stress treatments (
Figure 12). This indicated that IpASR might act as a transcription factor and thus regulate gene expression, with surplus IpASR elevating plant abiotic stress tolerance.
In summary, a salt- and drought-related gene, IpASR, from I. pes-caprae was characterized in this research. Our results indicated that IpASR belongs to ABA/water-deficit stress-related category (PF02496, ABA/WDS motif). The expression of IpASR is induced by mannitol, high salinity, MV, cold, and ABA. The overexpression of IpASR in E. coli and Arabidopsis displayed complex expression patterns involved in responses to abiotic stress, primarily salt and drought tolerance. Nonetheless, IpASR acts as a downstream factor in the response of plants to salinity and drought stresses and may be an important candidate gene for the molecular breeding of salt-tolerant plants. Our findings indicated that IpASR acts as a transcription factor, hydrophilic protein, or an ROS scavenger; and has a pleiotropic effect on physiological processes, thereby improving plant tolerance to multiple abiotic stresses. This report should help elucidate the molecular mechanisms of IpASR from I. pes-caprae in salt and drought resistance, and provides valuable information for the development of crops with enhanced abiotic stress tolerance, ultimately aiding breeding programs aimed at improving salt/drought tolerance.
4. Materials and Methods
4.1. Plant Materials, Growth Conditions, and Stress Treatments
The I. pes-caprae plants were cultivated in the South China Botanical Garden (23°18′75.91″ N, 113°37′02.38″ E) in Guangzhou city. The I. pes-caprae seeds were collected from the seaside of Zhuhai city (22°16′25.37″ N, 113°34′18.00″ E), Guangdong province, China. Different parts of I. pes-caprae were frozen in liquid nitrogen and stored at −80 °C until RNA isolation.
For I. pes-caprae seedling culture, the seeds were sterilized with 70% ethanol and then the seed coats were broken with emery paper prior to being placed onto Murashige and Skoog (MS) basal salts distributed into plates with sand and soil, and seedlings grew outdoors from April to November (2016) in the South China Botanical Garden. The seedlings were used for stress treatment assays to assess the expression patterns of IpASR. Subsequently, salt (300 mM NaCl), simulated drought or osmotic (300 mM mannitol), oxidative (0.1 mM methyl viologen), and cold (0 °C) stresses and ABA treatment (0.1 mM) were applied to the I. pes-caprae seedlings to detect the expression patterns of IpASR.
Arabidopsis thaliana (ecotype: Col-0) plants used for the ectopic expression experiments were grown on solid MS medium for about 10 days before being transferred to soil. All plants were incubated in a growth chamber at 22 °C and a photoperiod of 16-h light/8-h darkness.
4.2. Isolation of the Full-Length IpASR cDNA
A full-length cDNA library from I. pes-caprae was constructed and screened with the Full-length cDNA Over-eXpressor (FOX) gene hunting system using a yeast salt-sensitive mutant (AXT3) complementary assay approach (data not published). Thereafter, a full-length cDNA encoding the ASR protein (IpASR) that rescued the phenotype of AXT3 was selected and further investigated.
4.3. Sequence Analysis of the IpASR Gene
The full-length ASR cDNA sequence (GenBank accession no.: MF680587) was translated using the online ORFfinder translation tool (Available online:
https://www.ncbi.nlm.nih.gov/orffinder/). The ABA/WDS domain (Pfam entry PF02496) of the ASR protein was identified using the Pfam 31.0 server (Available online:
http://pfam.xfam.org/). The 3D prediction of IpASR was also conducted with the online program Protein Fold Recognition Server tool (PHYRE
2) (Available online:
http://www.sbg.bio.ic.ac.uk/phyre2/html/page.cgi?id=index). MEGA 6 was used for the protein homology comparisons and phylogenetic reconstruction using the neighbor-joining (NJ) method [
38]. Bootstrap values were estimated (with 1000 replicates) to assess the relative support for each branch. The IpASR protein was aligned with known plant ASRs using ClustalW software (Available online:
http://clustalw.ddbj.nig.ac.jp/).
The genomic sequence of
IpASR was also amplified with primer pairs IpASRPEF and IpASRPER (
Supplementary Materials Table S2). The genomic DNA of
I. pes-caprae was isolated with HiPure SF Plant DNA Kits (Magen, Guangzhou, China). The PCR product was inserted in pGEM T vector (Promega, Shanghai, China) and sequenced.
The protein sequences used were as follows: S. liaotungensis: SlASR (AGZ20206.1); S. brachiata: SbASR-1 (ACI15208.1); Camellia sinensis: CsASR (AHJ09608.1); Solanum chilense: ScASR (CBY05857.1); Mesembryanthemum crystallinum: McASR (AAC14177.1); Calystegia soldanella: CsoASR (BAB19963.1); Brachypodium distachyon: BdASR1 (XP_003565133.2); BdASR2 (XP_003567508.1); BdASR3 (XP_003567509.1); BdASR4 (XP_003577811.1); BdASR5 (KQJ82606.1); soybean: GmASR1 (NP_001336496.1); GmASR2 (NP_001237487.1); GmASR3 (XP_003536424.1); Ipomoea nil (morning glory): InASR (BAF46301.1); grape: VvASR (AAK69513.1); rice: OsASR1 (BAG88534.1); OsASR2 (BAS76319.1); OsASR3 (BAG89007.1); OsASR4 (XP_015633592.1); OsASR5 (BAG99580.1); OsASR6 (BAG87564.1); Maize: ZmASR1 (NP_001105361.2); ZmASR2 (NP_001278619.1); ZmASR3 (NP_001278619.1); ZmASR4 (NP_001152067.2); ZmASR5 (NP_001106235.1); ZmASR6 (XP_008645776.1); ZmASR7-1 (ONM32036.1); ZmASR7-2 (ONM32035.1); ZmASR7-3 (ONM32037.1); tomato: SlASR1 (Q08655.1); SlASR2 (P37219.1); SlASR3 (P37220.2); SlASR4 (AAY98032.1); SlASR5 (XP_004237807.1); apple: MdASR1 (XP_008340103.1); MdASR2 (XP_008358291.1); MdASR3 (XP_008348767.1); MdASR4 (XP_008381833.1); MdASR5 (XP_008381469.1).
4.4. Bacterial Overexpression and Salt, Osmotic, Dehydration, and H2O2 Tolerance Assays in E. coli
To further confirm the biological function of IpASR, the GST-IpASR fusion protein was inductively expressed in
E. coli. The coding sequence (CDS) of
IpASR was PCR-amplified using the primer pair (IpASREPF and IpASREPR) listed in
Supplementary Materials Table S2. The PCR fragments were subsequently inserted into the
BamHI site of pGEX 6p-1, followed by the GST-tag with the in-fusion technique (BD In-Fusion PCR cloning Kit, Takara Bio USA, Mountain View, CA, USA), thereby yielding the recombinant plasmid IpASR-pGEX 6p-1. The recombinant plasmid and empty vector pGEX 6p-1 (as a negative control) were then transformed into
E. coli BL21 (DE3). A single colony was then inoculated in liquid Luria-Bertani (LB) medium and allowed to grow overnight at 37 °C with constant shaking at 200 rpm. Inoculum (1%) from the overnight-grown culture was added to fresh LB medium (100 mL) containing 100 μg/mL of ampicillin and allowed to grow at 37 °C and 200 rpm. Expression was induced at an OD
600 of 0.5 by 0.2 mM isopropyl β-
d-thiogalactopyranoside (IPTG), and the cells were allowed to grow at 30 °C for 4 h with constant shaking at 200 rpm. The induced bacterial cells were harvested by centrifugation at 6000 rpm for 10 min at 4 °C, and the protein profiles were examined by 12% SDS PAGE.
A spot assay of E. coli was performed to test the stress tolerance of the IpASR protein, with three replicates for each sample. To evaluate salt, H2O2, and osmotic stress tolerance, cell cultures of E. coli (IPTG induced) containing pGEX 6p-1/IpASR-pGEX 6p-1 were adjusted to OD600 1.0 and then diluted serially (to 1:10, 1:100, and 1:1000). Two microliters of each sample was spotted onto the LB plates containing 0.2 mM IPTG and the stress component (5% or 6% NaCl, 2 M sorbitol, 5 or 8 mM H2O2). For the drought tolerance test, 1 mL OD-adjusted cell cultures in tubes were immediately placed in a 40 °C drying oven and maintained there for 4 h. Then, 100 μL liquid LB medium was added to the samples, which were then maintained at 37 °C for 1 h to recover. The samples were then diluted and spotted onto LB plates with 0.2 mM IPTG. The plates were incubated at 37 °C for 10 h. The bacterial colonies were counted (colony former unit, CFU) and the differences were analyzed.
We also performed a growth curve assay of recombinant E. coli in liquid LB culture to further confirm the functionality of IpASR. Briefly, 1 mL inoculum (OD600 value 1.0) was added to 10 mL LB medium (supplied with 0.2 mM IPTG) containing salt (3% or 4% NaCl), sorbitol (0.8 or 1 M), or H2O2 (0.7 or 0.9 mM) and incubated at 37 °C with shaking (180 rpm). The aliquots were removed from each treatment every 2 h from 2 to 12 h and absorbance (OD600) was measured. Abiotic stress (salt, osmotic and H2O2) tolerances were determined with respect to the control cultures (bacterial cells and empty vector pGEX 6p-1 controls).
4.5. Subcellular Localization Analysis
The CDS (without a termination codon) of the
IpASR gene was amplified by PCR using the primer pair IpASRGF and IpASRGR (
Supplementary Materials Table S2). The PCR product was inserted into the
BamHI site of the pUC/GFP vector to generate an IpASR-GFP in-frame fusion protein, following the in-fusion technique (Clontech, Mountain View, CA, USA), yielding the recombinant plasmid IpASR-pUC/GFP. After sequencing confirmation, the fusion construct and negative control (empty vector) were co-transfected into protoplasts (3 × 10
4 protoplasts) using polyethylene glycol (PEG)-calcium solution (0.4 g·mL
−1 PEG 4000, 0.2 M mannitol, 0.1 M CaCl
2). After washing and resuspending in W5 solution (154 mM NaCl, 125 mM CaCl
2, 5 mM KCl, 5 mM glucose, 2 mM MES, mesophyll protoplasts were incubated under white light for 12–18 h. Green fluorescent protein (GFP) fluorescence was visualized using a confocal laser scanning microscope (LSM, 510 META, Zeiss, Jena, Germany). The NLS-mCherry construction was co-transformed with the construction or empty vector as a nuclear localized marker.
4.6. Analysis of Transcriptional Activities in Yeast
The full-length CDS of IpASR and three truncated IpASRs were cloned into vector pGBKT7 (Clontech, Mountain View, CA, USA) for transcription activation analysis. These constructs along with the negative control pGBKT7 and pGBKT7-Lam plasmids, or positive control pGBKT7-53 plasmid, were transformed into
Saccharomyces cerevisiae strain AH109 using the lithium acetate mediated method according to the Yeast Protocols Handbook (Clontech, Mountain View, CA, USA), and the vector pGADT7-T was co-transformed with all of the above constructs and positive/negative contorls (pGBKT7-53, pGBKT7, and pGBKT7-Lam). The yeast clones was cultured in liquid SD-2 medium to OD
600 until 1.0, after which they were diluted using a gradient dilution (1:10, 1:100, and 1:1000). Two-microliter yeast cultures were spotted onto the corresponding synthetically defined (SD/-Trp/-Leu and SD/-Trp/-Leu/-His) medium plates for 2 days at 30 °C. Yeast transformation and determination of blue/white colonies were conducted according to the instructions of the manufacturer (Clontech), and X-α-Gal was used as a substrate for the reporter gene
MEL1. Primers used for plasmid construction are shown in
Supplementary Materials Table S2.
4.7. Expression Pattern Analysis
Total RNA was isolated from the
I. pes-caprae tissues using HiPure Plant RNA Kits (Magen, Guangzhou, China), and the cDNA was synthesized by TransScript One-Step gDNA Removal and cDNA Synthesis SuperMix (TransGen Biotech, Beijing, China) according to the manufacturer’s instructions. Quantitative reverse transcript PCR (qRT-PCR) was performed to examine the expression levels of
IpASR in the various tissues of the seedling and adult
I. pes-caprae plants, including seedling roots, seedling leaves, buds, mature roots, vines, mature leaves, flower buds, petals, and young seeds. The
I. pes-caprae seedling samples (roots, vines, and leaves), treated with salt, simulated drought or osmotic stress, oxidative stress, freezing stress, and ABA were also assessed to examine the expression changes of
IpASR. All of the gene expression data obtained via qRT-PCR were normalized to the expression of
IpUBQ (GenBank accession number: MF502417). The primers used for qRT-PCR are listed in
Supplementary Materials Table S2.
For detection of the expression of antioxidative related genes (
CAT1,
CAT2,
CSD1, and
FSD1) in
Arabidopsis (wild-type WT or transgenic plants), total RNA was isolated from the rosette leaves at different time points (with or without treatment), and cDNA synthesis was performed as per the above procedure. The reference gene for the RT-PCR was
ACT2 (At3g18780) in
Arabidopsis. The primers used for qRT-PCR are listed in
Supplementary Materials Table S2.
4.8. Generation of Transgenic Arabidopsis
To generate the recombinant vector for the overexpression assay in transgenic
Arabidopsis, the full-length cDNA of
IpASR was PCR-amplified using the primer pair IpASROXF and IpASROXR (
Supplementary Materials Table S2). The PCR product was cloned into the
BamHI site of the pBIm plasmid [
39] to generate IpASR-pBIm with an expression cassette under the control of the CaMV 35S promoter. After sequencing confirmation, the construct was transferred into
Agrobacterium tumefaciens GV3101 and then transformed into
Arabidopsis using the floral-dip method. Seeds of the T1 and T2 generations were screened on MS agar medium containing 50 mg/L kanamycin. Positive transgenic plants were selected according to the segregation ratio (resistant:sensitive = 3:1) and confirmed by genomic PCR with the primer pairs IpASROXF/IpASROXR. qRT-PCR and RT-PCR were also performed with primer pairs ASRF/ASRR and AtAct2F/AtAct2R (
Supplementary Materials Table S2) in order to identify the expression level of
IpASR in transgenic
Arabidopsis. 4.9. Stress Tolerance of Transgenic Arabidopsis
For the salt and osmotic stress tolerance assay, transgenic Arabidopsis T3 (IpASR OX3 and IpASR OX8) and WT were used. Sterilized seeds were germinated in MS medium under a 16-h photoperiod cycle at 25 °C, and 4-day-old seedlings were transplanted into medium supplemented with 100, 125, and 150 mM NaCl or 200, 300 and 400 mannitol. The germination rate and root length were measured. In brief, the seed germination rate of IpASR transgenic Arabidopsis was detected under NaCl (100, 125, 150, 175 and 200 mM) and mannitol (200, 300 and 400 mM) challenges on MS plates to assess whether the overexpression of IpASR could improve the salt and osmotic tolerance of the transgenic Arabidopsis seeds. The root length was also calculated to evaluate the influence of IpASR on the transgenic Arabidopsis seedlings under abiotic stress. The WT Arabidopsis was used as a control.
For salt and drought tolerance assays, 30 one-week-old seedlings of each genotype (IpASR OX3, IpASR OX8, and WT) were planted in sieve-like pots and watered well for two weeks. Prior to the salt/drought experiments, the plants of each genotype were cultured in a growth chamber as described above without watering for 10 days in order to ensure that the surrounding growing environment was devoid of excess water. The plants were then subjected to the following assays. For the drought tolerance assays, the WT and transgenic plants (IpASR OX3 and IpASR OX8) were maintained under drought conditions for 9 days, and were then re-watered for 7 days. For the salt tolerance assays, the plants of each genotype were planted in sieve-like pots and watered well, as described for the drought tolerance treatment. Water was withheld for 10 d before irrigating with NaCl solution (150 and 200 mM) from the bottom of the plates. When the soil was completely saturated with salt water, the NaCl solution was removed and the plants were cultured normally. The plants were grown in the salt-saturated soil for 10 days and then re-watered for 7 days. The survival rate of the Arabidopsis plants was measured once the entire assay was complete.
For the oxidative stress analyses of the transgenic overexpression lines and WT plants, 3-week-old seedlings of IpASR OXs and WT Arabidopsis plants in the soil were sprayed evenly with 20 μM and 50 μM methyl viologen (MV) for two times (first plants were sprayed for 3 time at beginning each pot, then second session plants were sprayed for 12 time on the 7th day each pot, one spray ≈ 100 μL), after which the plants were cultured normally for 14 days. The phenotype was recorded.
4.10. Physiological and Histochemical Analysis
The relative water content (RWC) of adult
Arabidopsis plants was determined as described according to Hu et al. [
28]. Fresh weight (FW) of rosette leaves were recorded followed by soaking the leaves for 4 h in distilled water at room temperature with constant light. After this treatment the turgid weight (TW) was recorded. The leaves were then dried for 24 h at 80 °C to obtain the total dry weight (DW). RWC was calculated from the equation: RWC (%) = [(FW − DW)/(TW − DW)] × 100%.
Rosette leaves were collected after each treatment, and IL (ion leakage) was measured with a DDS-307A conductivity meter (Shanghai Jingke, Shanghai, China), according to Hu et al. [
28] with slight modifications.
Arabidopsis rosette leaves were incubated in 20 mL double-distilled water at room temperature with occasional shaking for 12 h. Initial conductivity (C1) was measured with a conductivity meter followed by boiling of the samples for 30 min to measure complete IL. The leaves were then cooled to room temperature to measure the electrolyte conductivity (C2). IL was calculated according to the equation: IL (%) = C1/C2 × 100%.
Free proline content, malondialdehyde (MDA) content, and superoxide dismutase (SOD) and catalase (CAT) activities were determined using proline, MDA, SOD, and Catalase Assay Kits, according to the manufacturer’s instructions, respectively (Nanjing Jiancheng, Nanjing, China). In situ detection of H
2O
2 and O
2− was determined with 1 mg/mL nitro-blue tetrazolium (NBT) or 1 mg/mL 3,3′-diaminobenzidine (DAB) solution for 12 h and clearing in 96% ethanol, respectively, as previously described [
40].
4.11. Statistical Analysis
All the experiments in this study were repeated three times independently, and the data shown are the mean ± SD (n ≥ 3). Statistical analyses were performed using the statistical tools (Student’s t-test) of Microsoft Excel (Microsoft Corporation, Albuquerque, NM, USA).